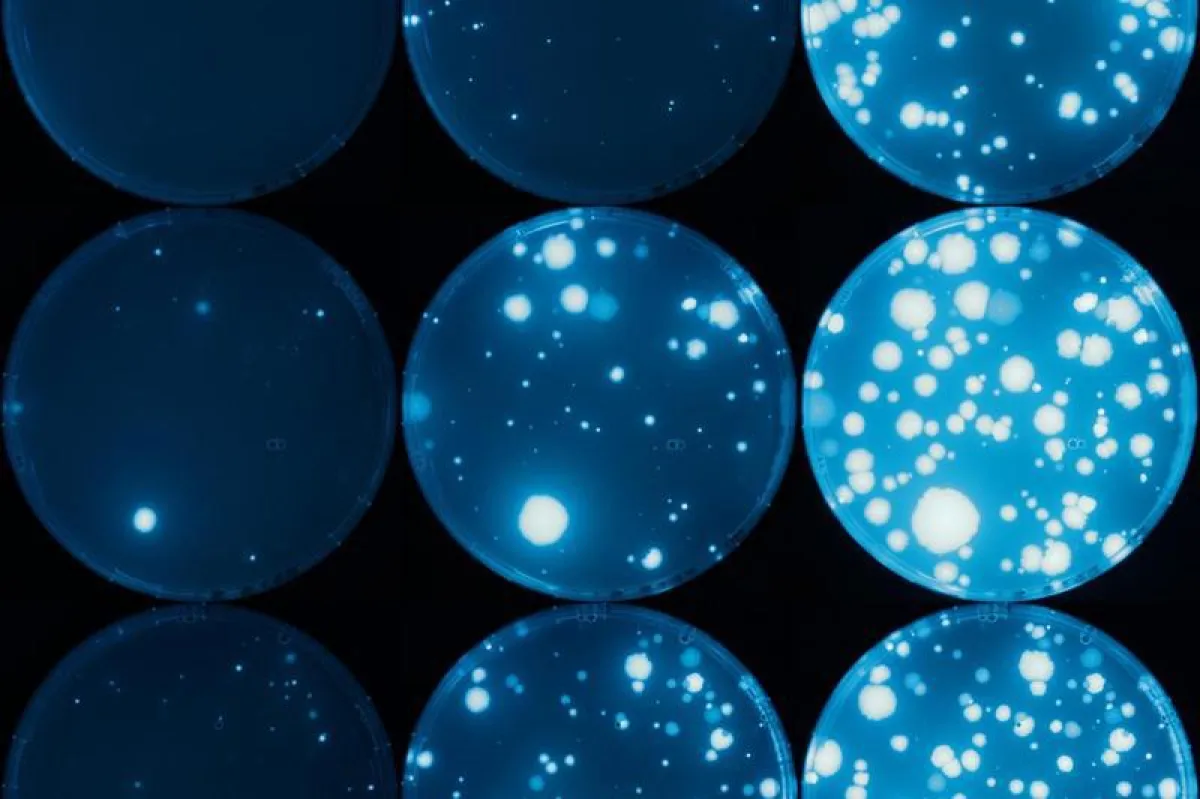
Bacterial colonies with a fluorescent reporter protein appearing on tetracycline plates over three days (left to right).  (Magdalena Steinrück)

(openPR) Genes do not exist in isolation. Like beads on a string, they sit next to each other on long DNA molecules called chromosomes. So far, little has been known about how the position of a gene on a chromosome affects its evolution. A new study by Calin Guet, Professor at the Institute of Science and Technology Austria (IST Austria), and Magdalena Steinrück, PhD student in Guet’s group, shows that a gene’s neighborhood can influence whether and how the activity of a gene changes. The study was published today in the open access journal eLife.
---
From bacteria to humans, the way organisms look and function depends a lot on how much product is made from each gene, in other words how active their genes are. The activity of a gene can be changed by mutations, alterations in the DNA that can be inherited. This can make the organism better adapted to its environment – or worse. For example, a bacterium that produces more of a protein that helps it get rid of an antibiotic may survive, while its competitors are killed by the antibiotic. In their study, Steinrück and Guet used experimental evolution to investigate how the position of a gene on the chromosome influences mutations that increase the activity of the gene.
The researchers engineered the DNA of the gut bacterium Escherichia coli to place an antibiotic resistance gene at different positions of its chromosome. This gene allows the bacterium to pump the antibiotic tetracycline out of the cell. At the start of the experiment, the gene was almost completely switched off. The researchers then added more and more tetracycline to the bacteria’s environment. This challenges the bacteria to switch the gene on by mutation, as producing more of the antibiotic resistance gene allows them to pump the antibiotic out, so that they multiply and survive. The authors found that the bacteria were much more likely to survive with the resistance gene in some places of the chromosome than at others. This is because the gene’s neighborhood affects which types of mutations can occur – some forms of mutations can only occur if the neighboring genes permit them to.
“We show that genes can influence the mutation and adaptive potential of nearby genes. The organization of genes on a chromosome is both cause and consequence of evolutionary change”, explains Calin Guet. Their research has vital implications, for example for the global health problem of antibiotic resistance. Magdalena Steinrück: “It is similar to the way humans develop: People in your neighborhood can influence greatly how your future looks like. Our study shows that antibiotic resistance developing from gene activating mutations depends strongly on the gene’s neighborhood.” Chromosome neighborhood effects have not been looked at in detail so far. In future, such findings could help to better estimate whether new antibiotic resistance is to be expected.
IST Austria
The Institute of Science and Technology (IST Austria) is a PhD granting research institution located in Klosterneuburg, 18 km from the center of Vienna, Austria. Inaugurated in 2009, the Institute is dedicated to basic research in the natural and mathematical sciences. IST Austria employs professors on a tenure-track system, postdoctoral fellows, and doctoral students at its international graduate school. While dedicated to the principle of curiosity-driven research, the Institute owns the rights to all scientific discoveries and is committed to promote their use. The first president of IST Austria is Thomas A. Henzinger, a leading computer scientist and former professor at the University of California in Berkeley, USA, and the EPFL in Lausanne, Switzerland.
www.ist.ac.at
Scientific contact:
Magdalena Steinrück
First author oft he study
Original publication:
Magdalena Steinrueck and Calin Guet:
“Complex chromosomal neighborhood effects determine the adaptive potential of a gene under selection”, elife July 25, 2017
https://doi.org/10.7554/eLife.25100
Quelle: idw